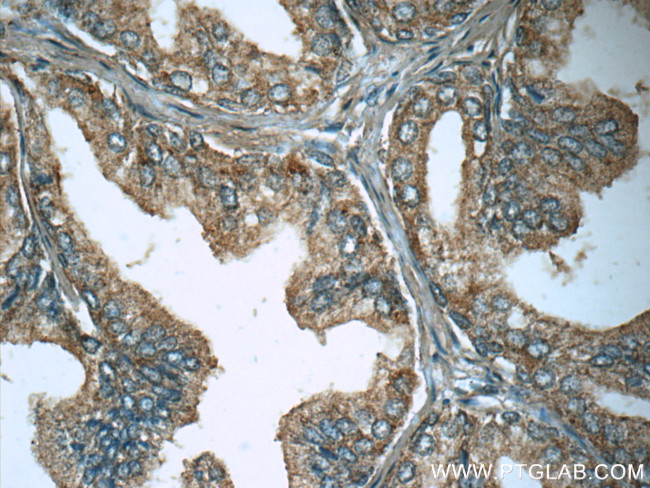
Lactoferrin Antibody in Immunohistochemistry (Paraffin) (IHC (P))

Search
Proteintech
Lactoferrin Polyclonal Antibody
{{$productOrderCtrl.translations['antibody.pdp.commerceCard.promotion.promotions']}}
{{$productOrderCtrl.translations['antibody.pdp.commerceCard.promotion.viewpromo']}}
{{$productOrderCtrl.translations['antibody.pdp.commerceCard.promotion.promocode']}}: {{promo.promoCode}} {{promo.promoTitle}} {{promo.promoDescription}}. {{$productOrderCtrl.translations['antibody.pdp.commerceCard.promotion.learnmore']}}








Please note: We are reviewing Western blot images included in the antibody testing data in our catalog, including those provided by third parties. Unless expressly labeled or annotated as “raw-unedited”, Western blot images included in the antibody testing data in our catalog may have been edited, optimized or otherwise adjusted for presentation.
产品信息
10933-1-AP
种属反应
已发表种属
宿主/亚型
分类
类型
抗原
偶联物
形式
浓度
规格
纯化类型
保存液
内含物
保存条件
运输条件
产品详细信息
Immunogen sequence: TAIQNLRKS EEEVAARRAR VVWCAVGEQE LRKCNQWSGL SEGSVTCSSA STTEDCIALV LKGEADAMSL DGGYVYTAGK CGLVPVLAEN YKSQQSSDPD PNCVDRPVEG YLTVAVVRRS DTSLTWNSVK GKKSCHTAVD RTAGWNIPMG LLFNQTGSCK FDEYFSQSCA PGSDPRSNLC ALCIGDEQGE NKCEPNSNER YYGYTGAFRC LAENAGDVAF VKDVTVLQNT DGNNNEAWAK DLKLADFALL CLDGKRKPVT EARSCHLAMA PNHAVVSRMD KVERLKQVLL HQQAKFGRNG SDCPDKFCLF QSETKNLLFN DNTECLARLH GKTTYEKYLG PQYVAGITNL KKCSTSPLLE ACEFLRK (346-711 aa encoded by BC015822 )
靶标信息
Lactoferrin (LF) is an iron binding glycoprotein. LF consists of a single polypeptide chain (approximately 80 kDa) folded into two structurally homologous lobes, each of which can reversibly bind one ferric ion (Fe3+). LF is found in external fluids, including milk and mucosal secretions, and is a prominent component of secondary granuals of neutrophils. The protein demonstrates a broad spectrum of properties, including regulation of iron homeostasis, host defense against a broad range of microbial infections, anti-inflammatory activity, regulation of cellular growth and differentiation and protection against cancer development and metastasis. LTF acts as a major first line defense against microbial infections, partly due to its ability to efficiently bind to and hence remove Fe3+ from the environment, but studies have also shown that LTF possesses bactericidal properties and proteolytic activity, capable of cleaving arginine-rich sequences within microbial proteins. Three isoforms of LTF have been identified: LTF-alpha, LTF-beta and LTF-gamma and receptors for LTF are expressed in the gastrointestinal tract, by macrophages, lymphocytes, neutrophils and platelets and also by some bacteria.
仅用于科研。不用于诊断过程。未经明确授权不得转售。
生物信息学
蛋白别名: CKRX; Growth-inhibiting protein 12; Kaliocin 1; Kaliocin1; Lactoferricin H; Lactoferrin; LactoferroxinA; LactoferroxinB; LactoferroxinC; Lactotransferrin; Lfcin H; LfcinH; Talalactoferrin
基因别名: GIG12; LF; LTF
Entrez Gene ID: (Human) 4057